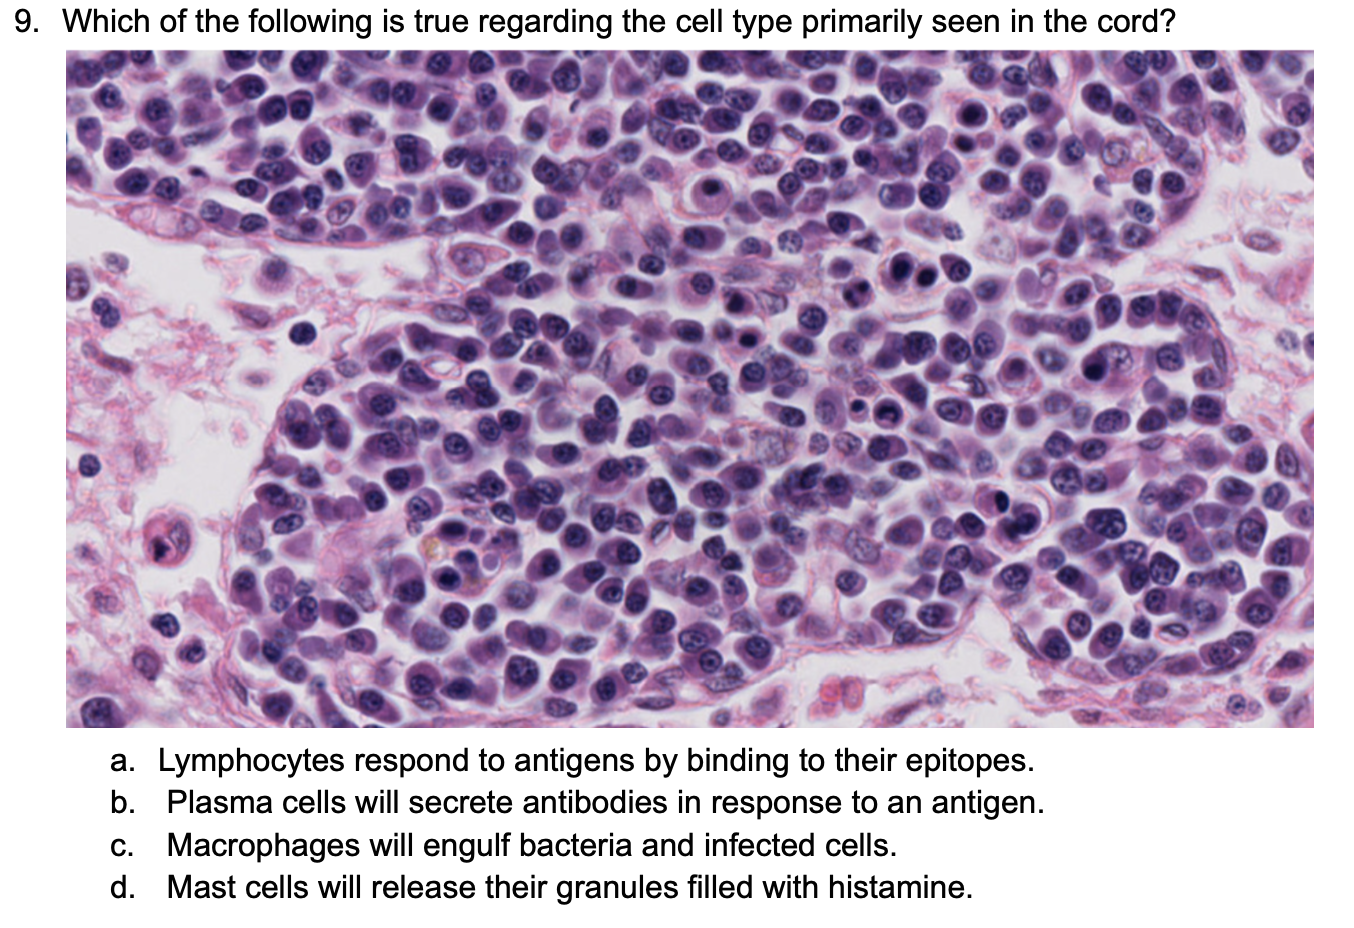
term image
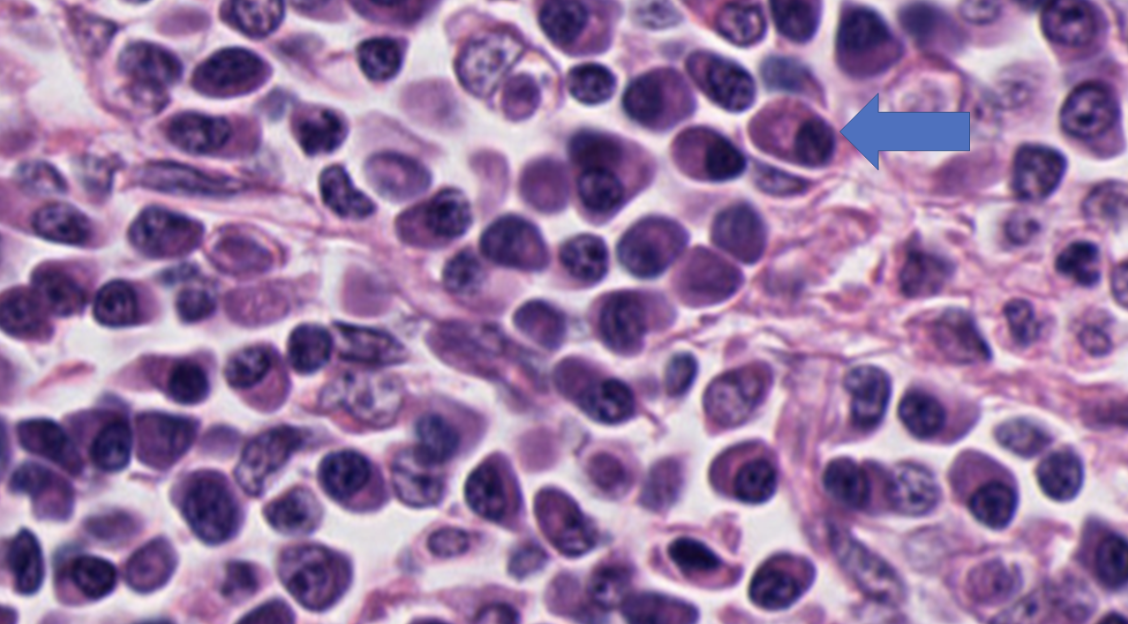
<p><span>The arrow is pointing to which cell?</span></p><p>-Plasma Cell</p><p>-Mast Cell</p><p>-Macrophage&nbsp;</p><p>-Neutrophil</p><p>-Lymphocyte</p>
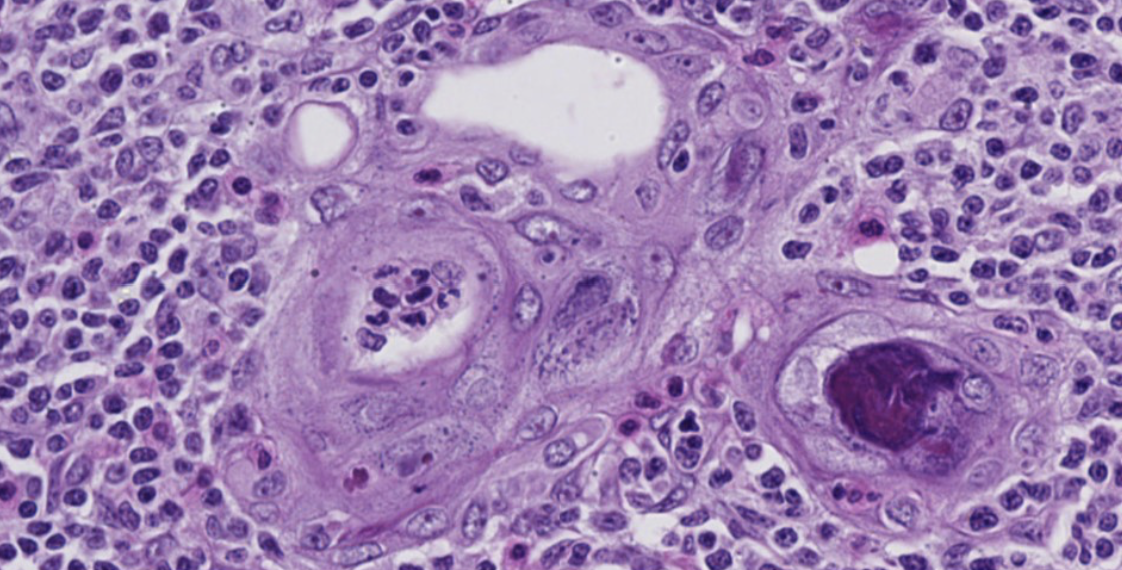
<p><span>Which of the following is FALSE about the image below?</span></p><p><span>-</span>It is in the thymus cortex</p><p>-It contains more mature thymocytes that are less densely packed</p><p>-It contains Hassall’s Corpuscles that are concentric layers of epithelial reticular cells that are degenerating</p><p>-It contains dendritic antigen-presenting cells</p>

1/155
Looks like no tags are added yet.
Name | Mastery | Learn | Test | Matching | Spaced | Call with Kai |
|---|
No analytics yet
Send a link to your students to track their progress

Which of the following is true in regard to antigen-antibody interactions?
-A single antibody can respond to hundreds or thousands of different antigens
-A single cell will only produce a single type of antigen
-Antibodies can only respond to the exact antigen they were made for
-None of the above are true


The arrows are pointing to which cells?
-Plasma Cells
-Mast Cells
-Macrophages
-Neutrophils
-Lymphocytes

The arrow is pointing to which cell?
-Plasma Cell
-Mast Cell
-Macrophage
-Neutrophil
-Lymphocyte

Which of the following cells are considered tissue bound?
-Mast cells, macrophages, and lymphocytes
-Lymphocytes, plasma cells, and monocytes
-Monocytes, neutrophils, and lymphocytes
-Mast cells, macrophages, and plasma cells
-Mast cells, macrophages, and plasma cells

Which of the following is true regarding the image of the lymph node?
-The nodules/follicles are secondary, so the lymph node is responding to antigens.
-The nodules/follicles are secondary, so the lymph node is not responding to antigens.
-The nodules/follicles are primary , so the lymph node is responding to antigens.
-The nodules/follicles are primary, so the lymph node is not responding to antigens.

What is true about the function of Epithelial Reticular Cells?
-They provided the structural framework for lymph nodes
-They create the blood-thymus barrier
-They help in positive and negative selection of macrophages
-None of the above

Which of the following is true about the cells in the thymus cortex?
-Thymocytes are very densely packed
-Macrophages ingest apoptotic thymocytes
-Epithelial reticular cells are mainly structural and make the blood-thymus barrier
-All of the above

Which of the following is FALSE about the image below?
-It is in the thymus cortex
-It contains more mature thymocytes that are less densely packed
-It contains Hassall’s Corpuscles that are concentric layers of epithelial reticular cells that are degenerating
-It contains dendritic antigen-presenting cells

Which of the following is correct when a lymph node responds to an antigen?
-B lymphocytes proliferate in the germinal centers, move out of the nodule, differentiate into plasma cells which will then make antibodies.
-T lymphocytes proliferate in the germinal centers, move out of the nodule, differentiate into plasma cells which will then make antibodies.
-B lymphocytes proliferate in the germinal centers, move out of the nodule, differentiate into macrophages which will then make antibodies.
-T lymphocytes proliferate in the germinal centers, move out of the nodule. differentiate into macrophages which will then make antibodies.

Which of the following statement is true regarding the image of the lymph node?
-The nodules/follicles are secondary, so the lymph node is responding to antigens.
-The nodules/follicles are secondary, so the lymph node is not responding to antigens.
-The nodules/follicles are primary, so the lymph node is responding to antigens.
-The nodules/follicles are primary, so the lymph node is not responding to antigens.
